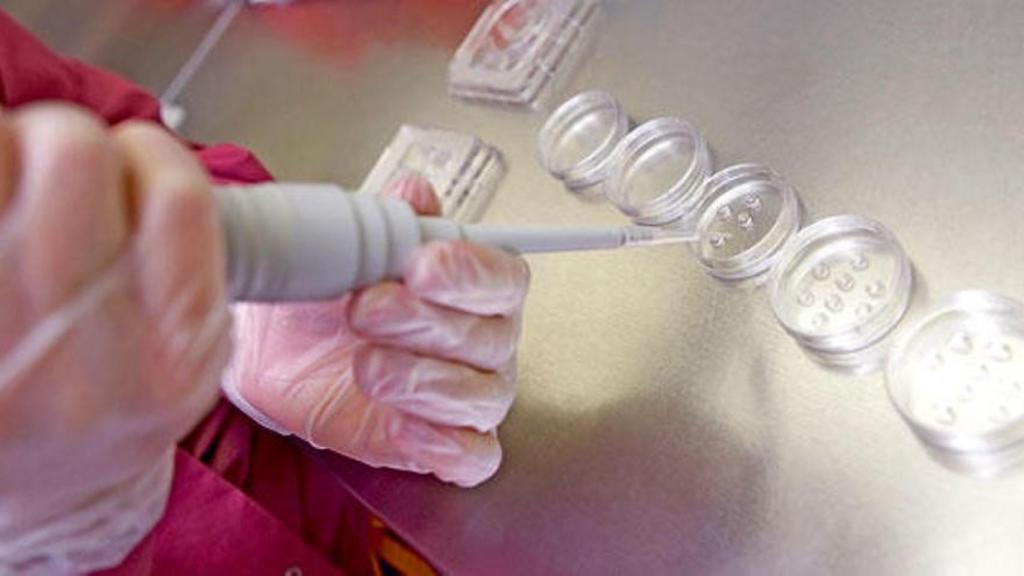
Proceso de selección de embriones en un laboratorio.

Manos de hombres y mujeres pintadas de rosa por el Día Mundial de la Lucha contra el Cáncer de Mama. EFE
La historia de las "previvientes", mujeres con una mutación genética que viven esperando el cáncer
Las personas con gen BRCA tienen hasta un 70 % de probabilidades de desarrollar la enfermedad. Su vida es una toma de decisiones constante, aún estando sanas.
En Estados Unidos se las conoce como "previvors", lo que podría traducirse como "previvientes": mujeres que tienen una posibilidad muy alta de padecer cáncer de pecho o de ovario debido a una mutación hereditaria conocida como BRCA, y se han visto obligadas a recurrir a tratamientos profilácticos como medida preventiva aunque aún no hayan desarrollado la enfermedad.
Se extirpan a una edad temprana partes de su cuerpo en base a estadísticas y opiniones médicas, algunas veces contradictorias, con la esperanza de no desarrollar nunca el cáncer que lleva generaciones en su familia. Han visto cómo sus parientes han muerto sin saber siquiera que tenían una predisposición medible en sus genes. Y se enfrentan al dilema de ser madres lidiando con la maquinaria burocrática de la Administración, que dispone de los instrumentos para romper la cadena pero que tiende a complicar la toma de decisiones con la ausencia de un protocolo que agilice las intervenciones.
Las mutaciones BRCA afectan aproximadamente a 1 de cada 400 personas. Se dan indistintamente en hombre y en mujeres, aunque los primeros suelen desarrollar cáncer de próstata y las segundas se enfrentan a unas altas probabilidades de tenerlos de mama o de ovarios, aunque también hay casos de páncreas. Es por esto por lo que se les recomienda que, "cuanto antes", se sometan a operaciones para extirpar estas partes de su cuerpo, limitando algunos aspectos esenciales de su vida como la sexualidad o la maternidad.
Las personas con BRCA, previvientes a partir de ahora, se encuentran en medio de ninguna parte: muchas de ellas no tienen aún la enfermedad pero sus posibilidades de desarrollarla se pueden elevar hasta el 75 %, lo que les fuerza a tomar decisiones "casi a ciegas" e incluso "con un perfecto estado de salud". Pero no tienen alternativa si no quieren tener que lidiar con la certeza de un diagnóstico tardío.
En España no solo no existe ningún término para definirlas, sino que se encuentran completamente al margen de la concepción social habitual que se tiene del cáncer. Normalmente es sencillo: o lo tienes o no lo tienes. Pero ¿qué pasa con quienes están obligadas a sobrevivir a la enfermedad antes siquiera de que aparezca?
EL ESPAÑOL ha hablado con tres de estas mujeres, residentes en la Comunidad Valenciana, donde han encontrado importantes taras en el sistema. Sus nombres son ficticios porque su situación especial puede perjudicarles en el día a día: tanto a la hora de contratar un seguro médico como buscando un empleo, el BRCA es un estigma silencioso que condiciona vidas enteras a partir de un mapa genético que ha empezado a desentrañarse hace relativamente poco.
50/50
Noelia tiene 39 años y sabe que está genéticamente predispuesta al cáncer desde los 35. Le vino por parte de padre, a quien diagnosticaron un cáncer de próstata cuando ya le había "saltado a los huesos". Sus tres tías fallecieron a una edad temprana, lo que hizo saltar las alarmas en su familia. Su padre se hizo la prueba y dio positivo en BRCA, al igual que Noelia. Su hermana, negativo.
La probabilidad de heredar la mutación es del 50/50. Hay estudios que dicen que existe una prevalencia más alta en algunas poblaciones, como la holandesa, noruega o islandesa, pero por regla general en España tener el gen o no tenerlo depende básicamente de tirar una moneda al aire.
["Del cáncer se puede salir", la valenciana Rocío Calvo habla de las secuelas de la enfermedad]
A partir de ese momento, relata Noelia, la vida de una previviente pasa por "anticiparse a una probabilidad". Ella acababa de ser madre y estaba dando el pecho cuando los médicos le instaron a quitarse las mamas. Aquí vino el primer problema: el oncólogo decía que la intervención tenía que ser inmediata, pero desde cirugía le recordaban que, al haber acabado de dar de mamar, aún seguía generando leche y podía haber infección.
"Te plantean la situación, pero al final quien tiene que decidir eres tú", relata. "Y es muy complicado, porque es que tú estás sano". Noelia tuvo que buscar asesoramiento en la medicina privada para saber qué hacer. Finalmente dio el paso y en septiembre de 2018 se sometió a una mastectomía y posterior reconstrucción. Y ahí encontró el siguiente problema: buscar el apoyo de personas en su misma situación y que hubiesen vivido lo que estaba pasando ella.
"Te quitas una parte de tu cuerpo que afecta a aspectos íntimos muy importantes de tu vida, como tu sexualidad. Y buscas asesoramiento en asociaciones de cáncer, porque al final es el lugar natural al que acudir. Pero no hay nada: ni grupos de apoyo para personas con BRCA, ni información específica", explica. "Al final tienes que buscar a otras personas por tu cuenta, y da la sensación de que estamos un poco olvidadas".
También habla del problema que supone la mutación en el día a día: "Nos dicen que seamos discretas con nuestra situación porque podemos tener problemas con los seguros médicos o incluso laborales". En este último caso, porque "saber que tienen una alta probabilidad de tener cáncer disminuye las posibilidades de que una empresa te quiera contratar". "Es como un gran tabú, somos personas que no estamos ni dentro ni fuera del cáncer. Pero seguimos existiendo", añade.

Prueba para detectar el cáncer de mama, en imagen de archivo. EFE
Su dilema actual es quitarse los ovarios. Y aquí destaca los "problemas de organización" a los que se enfrenta la Sanidad pública: "No hay un protocolo ni entre comunidades ni entre hospitales o profesionales del mismo sistema de salud". Sus revisiones, por ejemplo, se hacen cada seis meses, mientras algunas de sus compañeras las pasan anualmente. En el caso de los ovarios, la primera opinión médica que tuvo fue "esperar hasta los 45" porque no había antecedentes familiares.
Todo cambió cuando acudió a la revisión ginecológica y comprobó que tenía un quiste, aunque era antiguo. Le dijo que le convenía quitarse ese ovario o las trompas de Falopio. Noelia acudió a continuación al Consejo Genético y allí la instaron a vaciarse por completo, justo lo contrario que la primera valoración que tuvo.
[Muere Charlie, el 'tiktoker' alicantino que luchaba contra el cáncer: "Nos vemos en otra vida"]
¿Cómo afecta esta situación a su salud mental? "Son muchos factores. El estrés, la alimentación, la vida en pareja... echo en falta que nos proporcionen más recursos para afrontar lo que se nos viene encima". También apunta a que hay notas positivas: "Una parte de mí está agradecida a todo esto. He aprendido a disfrutar de todo, y mis revisiones las encuentro como un recordatorio de que estoy viva. En parte me ha ayudado a vivir mejor".
El BRCA, dice, "te marca completamente tu vida. Tanto para bien como para mal. De las situaciones difíciles también aprendes. Somos todos conscientes de que vamos a morir, pero es verdad que vives más intensamente las cosas".
Ser madre con BRCA
Uno de los dilemas más frecuentes a los que se enfrentan las mujeres previvientes es la posibilidad de ser madre. Sus hijos tienen una probabilidad del 50 % de adquirir la mutación, y esta no se puede detectar hasta que él o ella decidan someterse voluntariamente a la prueba al cumplir los 18 años.
Este es el caso de María, de 28 años. Su madre superó un cáncer de mama y otro de ovario. De este último falleció su abuela. En su familia son tres hermanos: tanto ella como su hermano dieron positivo en BRCA nada más alcanzar la mayoría de edad, mientras que su hermana mayor es negativa.
"Desde el mismo momento en el que te lo detectan te dicen que tienes que controlarte y, sobre todos, tener hijos muy pronto". Las posibilidades de desarrollar un cáncer de ovario son altas, y cuanto antes se extirpen mejor. La ventaja es que, con la tecnología médica actual, existe la posibilidad de romper la cadena de transmisión de la enfermedad dentro de una familia y permitir que las generaciones futuras nazcan sin ese lastre.
Se llama diagnóstico genético preimplantacional, y consiste en una fecundación in vitro en el que se analizan las células de los embriones y se seleccionan aquellos que no tienen BRCA. El problema es que la inclusión de esta técnica en los servicios públicos de salud va por autonomías, así que, cuando María se planteó ser madre, tuvo que recurrir a la Sanidad privada. El coste total era de "unos 20.000 euros". "Como comprarte un coche", ironiza.
Tras someterse a las pruebas, el consejo nacional de genética aprobó su petición. Y fue justo ahí cuando la Comunidad Valenciana informó de que incorporaba a su cartera de servicios el diagnóstico genético preimplantación. Era noviembre de 2021 y María decidió pasarse a la pública esperando una solución rápida.
Lo que ha encontrado desde entonces son "trabas burocráticas constantes" que van retrasando la decisión en un contexto donde la toma de decisiones rápidas resulta crítica. "Se vuelve a enviar la documentación, parece que no existe un protocolo definido y al final todo se reduce a que tienes que esperar constantemente", afirma.
Proceso de selección de embriones en un laboratorio. EFE
Mientras tanto, la vida sigue. María habla de la importancia de afrontar esta situación "con estabilidad", tanto laboral como personal. "Al final no solo es tu vida. Cuando te dicen que tienes que tener hijos pronto por tu situación, es una decisión que afecta directamente a tu pareja. Y yo he tenido la suerte de que en todo momento he contado con su apoyo".
Eso no quiere decir que el desgaste no la afecte: "He aprendido a vivir con esto en el fondo de mis pensamientos. Una vez al año me llamaban para darme apoyo psicológico y lo sacaba todo. Pero al final todo se traduce a esperar. Para tener hijos, para quitarme las mamas... el tiempo va en nuestra contra, y el sistema no parece diseñado para hacérnoslo más fácil".
Contrarreloj
En una situación muy parecida se encuentra Valentina. Con 39 años, la cuenta atrás para ser madre está ya en números rojos. Tiene una mastectomía programada para dentro de siete meses. Lleva años pelando por poder someterse al tratamiento de selección embrionaria, pero no para de encontrarse con "muros" dentro del sistema público de salud.
"Hay diferencias notables entre los mismos hospitales de la Comunidad Valenciana. Tanto por los controles como la coordinación entre especialistas", apunta. "Y si el protocolo que se sigue no es el mismo, la capacidad de detección no va a ser igual".
[La historia agridulce de la familia de Lucas, el niño alicantino que ha ganado al cáncer]
Valentina narra un sinfín de problemas desde que la Conselleria decide incluir en su cartera de servicios el diagnóstico genético preimplantación. Desde documentación que no llega hasta la falta de comunicación entre departamentos de un mismo sistema público y, "por supuesto, entre comunidades".
El resultado: que todo se retrasa. "Me llamaron para estar en noviembre en la unidad de reproducción asistida. Hasta enero no empezamos a hacer ningún tipo de prueba. Tienen que decir que eres apto para hacer esta actividad. En marzo ya estaba todo listo, y se envió los papeles a la jefa de unidad de Conselleria. No tuvimos noticias hasta mayo, pero porque insistimos y se dieron cuenta de que el correo que se había quedado en Gerencia y no se había remitido Y todo así".
Tampoco ayuda que en la región haya solo cuatro hospitales que realicen pruebas para este tratamiento (tres en Valencia y uno en Alicante) y todos ellos, explica Valentina, "tienen diferentes formas de actuar". En algunos casos los centros ya han hecho los "estudios de informatividad", que tardan unas seis semanas y que consiste en hacer analíticas a la persona afectada, a su pareja y a un familiar también con BRCA; en otros, como el suyo, no harán la prueba hasta que no se cumplan el resto de pasos. "Es desesperante".
La cuestión es que, un año después, "no hay nadie que tenga una respuesta de lo que está pasando. No sabemos por qué tardamos tanto en avanzar, pero necesitamos una solución rápida porque algunas no tenemos mucho tiempo".
[El peor desenlace del cáncer infantil vivido por 'Lucía, mi pediatra' en su centro de Alicante]
Valentina reconoce estar "hasta las narices" de pelear con la Administración. "Te dan la noticia y prácticamente te abandonan. Eres BRCA, tienes que hacerte una serie de controles, extirparte las mamas... pero no hay un apoyo psicológico detrás que te apoye en la toma de decisiones, ni hay un control de los casos por parte de un equipo multidisciplinar. No saben en qué punto te encuentras".
Según apunta, "esta situación te empuja a que busques soluciones en la sanidad privada, dejándote el dinero. Al final los años pasan y tú sigues igual. No sabes en qué momento vas a desarrollar un cáncer, y mientras te va afectando a nivel psicológico, de pareja y laboral". Las decisiones que toman, mientras tanto, son permanentes. Y con el único objetivo de poder continuar con sus vidas.




